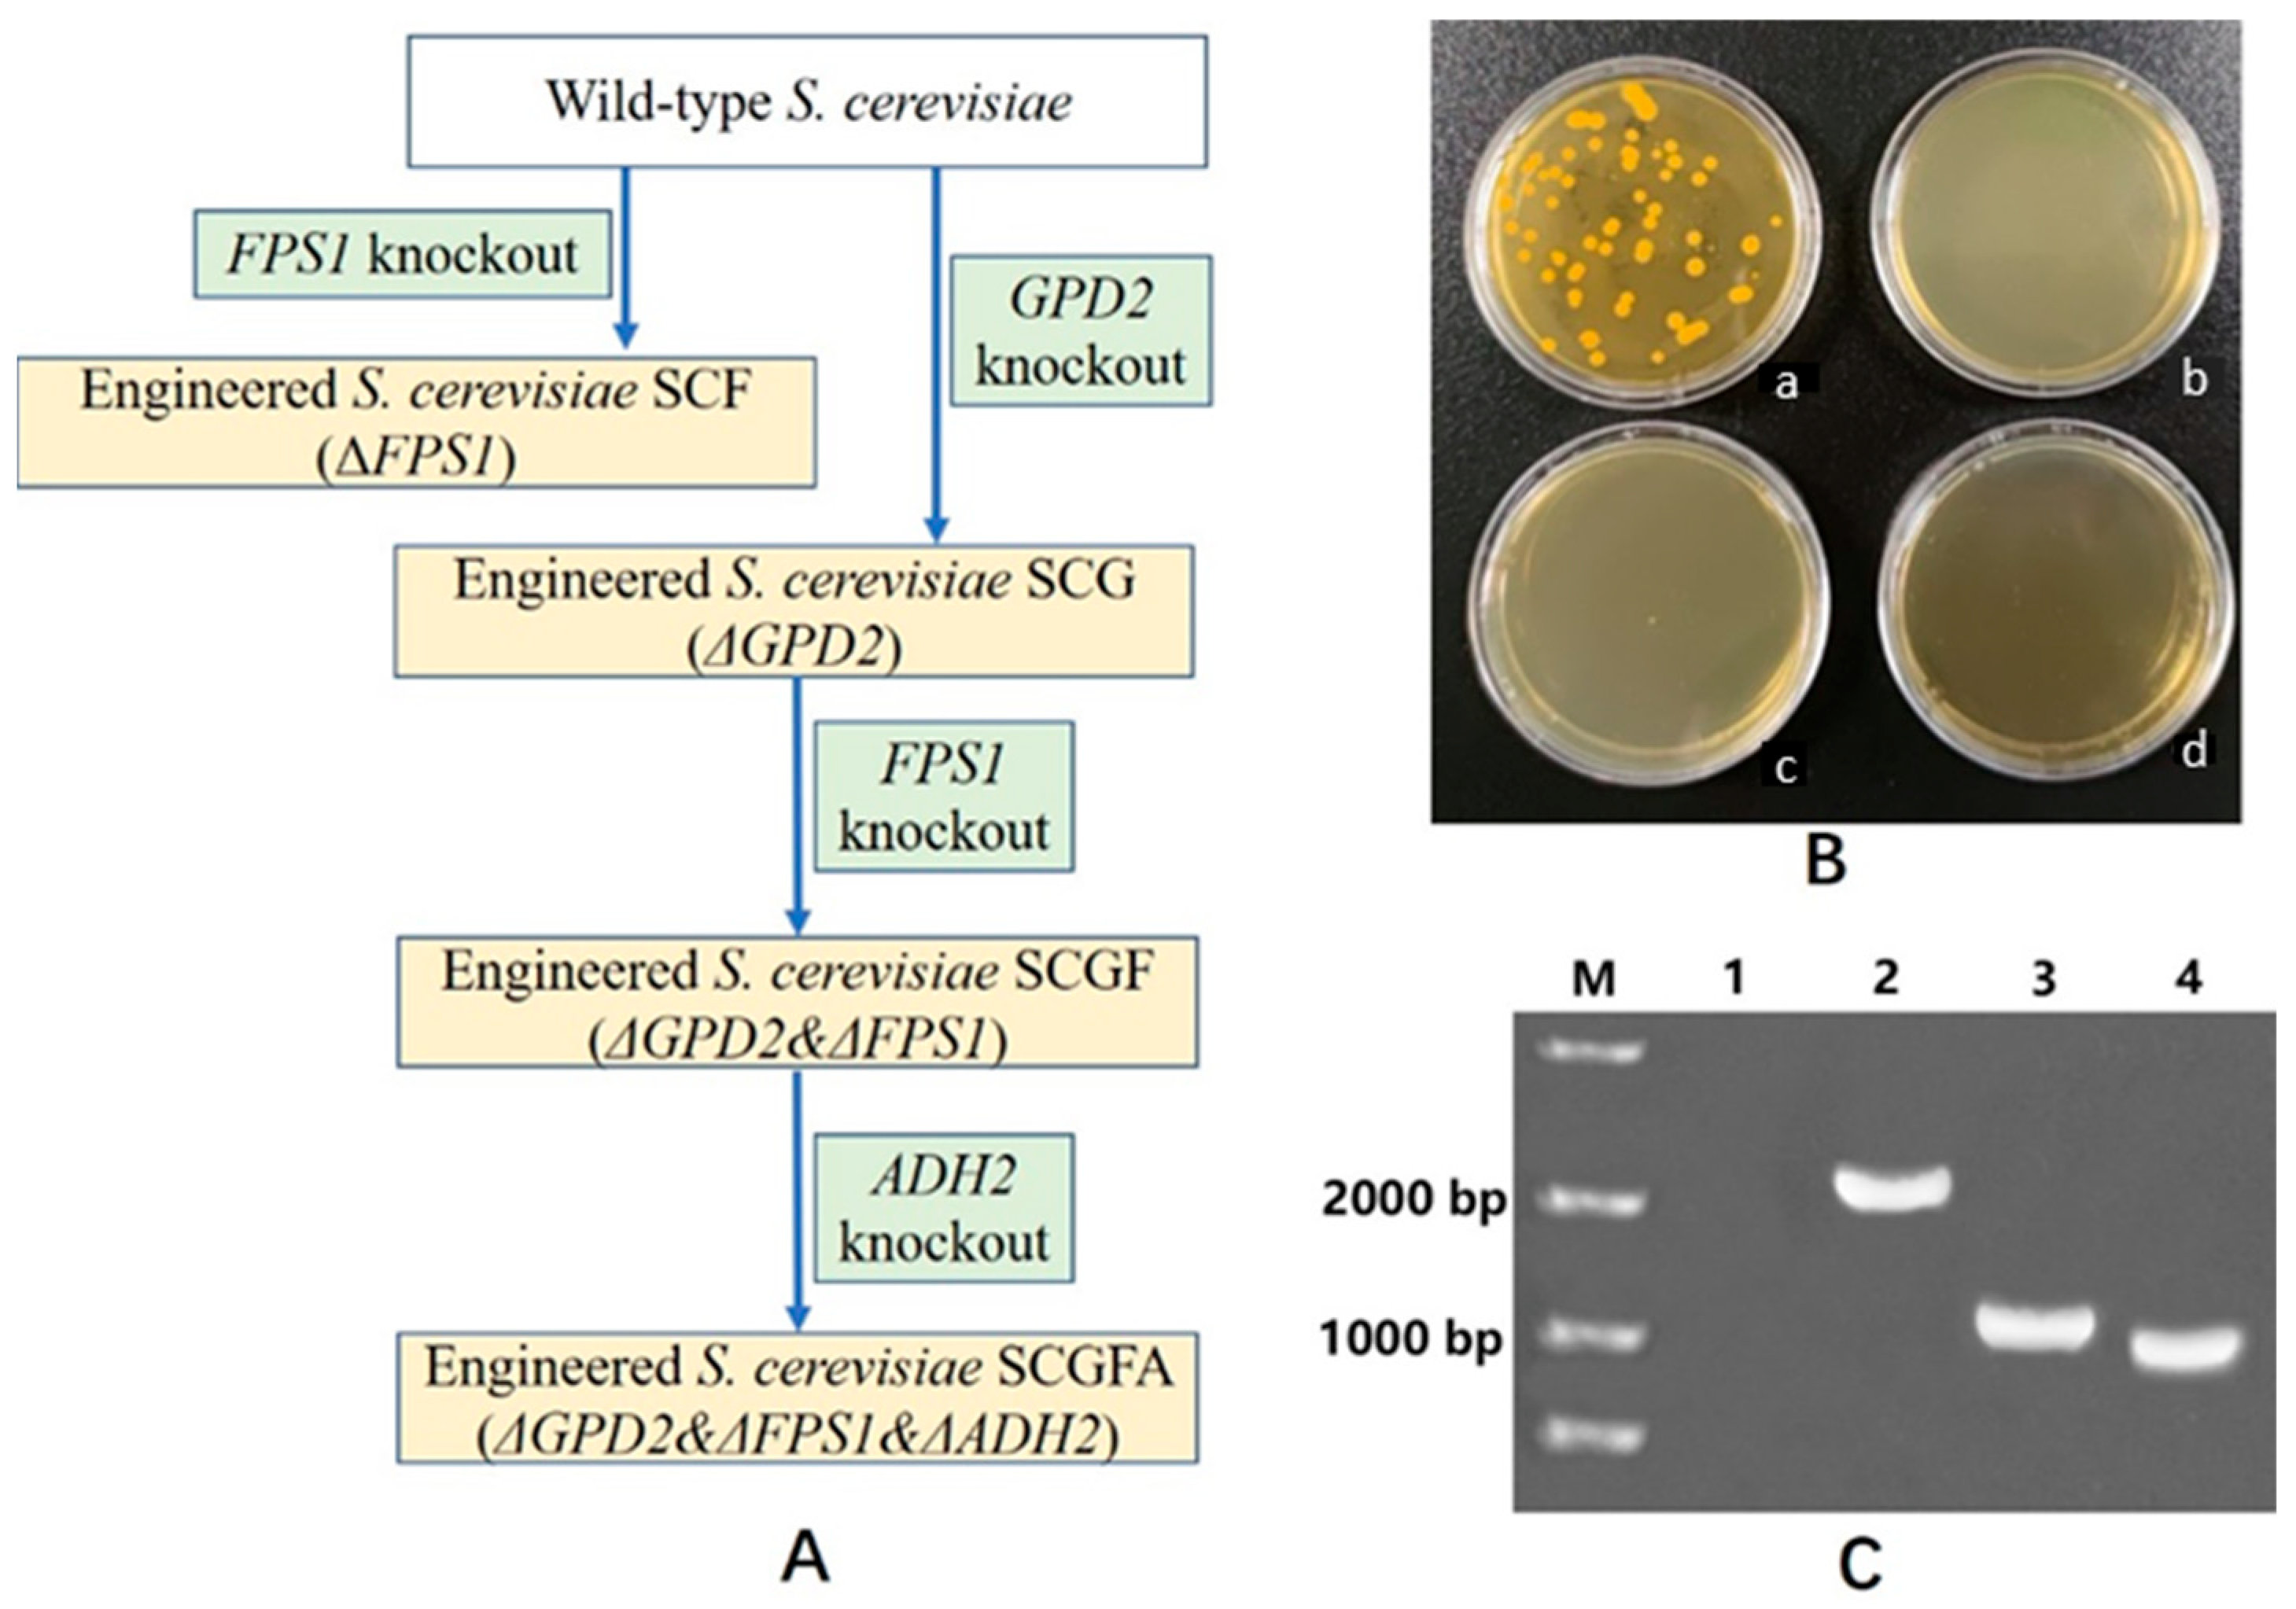
Jof 08 00703 g003

CRISPR-Cas9 Approach Constructed Engineered Saccharomyces cerevisiae with the Deletion of GPD2, FPS1, and ADH2 to Enhance the Production of Ethanol
Abstract
:1. Introduction
2. Materials and Methods
2.1. Plasmids, Primers, and Agents
2.2. Linear Vector Construction for gRNA Synthesis
2.3. S. cerevisiae GPD2, FPS1, and ADH2 Knockout by CRISPR-Cas9 Approach
2.4. Identification of Engineering Strains by DNA Amplification and Sequencing
2.5. Growth Determination of Engineered S. cerevisiae
2.6. Sample Treatment for the Content Measurement of By-Products
2.7. Determination of By-Products by the HPLC Method
2.8. Transcriptome Analysis
2.9. Data Analysis
3. Results
3.1. Engineered S. cerevisiae Construction
3.2. Effect of Gene Deletion on the Proliferation of S. cerevisiae
3.3. Effect of Gene Knockout on the Glucose Consumption
3.4. Effect of Gene Deletion on the Ethanol Production
3.5. Glycerol Production of Engineered S. cerevisiae
3.6. Lactic Acid Production of S. cerevisiae
3.7. Effect of Gene Knockout on the Production of Acetic Acid
3.8. Succinic Acid Production during the Fermentation of S. cerevisiae
3.9. Comparison of CO2 Concentrations of the Wild-Type and Engineered Strains
3.10. Stability of Ethanol Production by SCGFA Engineering Strain
3.11. Carbon Balance Analysis
3.12. Differentially Expressed Genes (DEGs)
3.13. Function Annotation of Differential Genes
3.14. KEGG Analysis
4. Discussions
5. Conclusions
Author Contributions
Funding
Institutional Review Board Statement
Informed Consent Statement
Data Availability Statement
Conflicts of Interest
References
- Kumari, D.; Singh, R. Pretreatment of lignocellulosic wastes for biofuel production: A critical review. Renew. Sustain. Energy Rev. 2018, 90, 877–891. [Google Scholar] [CrossRef]
- Ha, S.J.; Galazka, J.M.; Kim, S.R.; Choi, J.H.; Yang, X.M.; Seo, J.H.; Glass, N.L.; Cate, J.H.D.; Jin, Y.S. Engineered Saccharomyces cerevisiae capable of simultaneous cellobiose and xylose fermentation. Proc. Natl. Acad. Sci. USA 2011, 108, 504–509. [Google Scholar] [CrossRef] [PubMed] [Green Version]
- Watcharawipas, A.; Sae-tang, K.; Sansatchanon, K.; Sudying, P.; Boonchoo, K.; Tanapongpipat, S.; Kocharin, K.; Runguphan, W. Systematic engineering of Saccharomyces cerevisiae for D-lactic acid production with near theoretical yield. FEMS Yeast Res. 2021, 21, 15. [Google Scholar] [CrossRef] [PubMed]
- Milne, N.; Wahl, S.A.; van Maris, A.J.A.; Pronk, J.T.; Daran, J.M. Excessive by-product formation: A key contributor to low isobutanol yields of engineered Saccharomyces cerevisiae strains. Metab. Eng. Commun. 2016, 3, 39–51. [Google Scholar] [CrossRef]
- Remize, F.; Barnavon, L.; Dequin, S. Glycerol export and glycerol-3-phosphate dehydrogenase, but not glycerol phosphatase, are rate limiting for glycerol production in Saccharomyces cerevisiae. Metab. Eng. 2001, 3, 301–312. [Google Scholar] [CrossRef]
- Sarris, D.; Papanikolaou, S. Biotechnological production of ethanol: Biochemistry, processes and technologies. Eng. Life Sci. 2016, 16, 307–329. [Google Scholar] [CrossRef] [Green Version]
- Zhang, A.L.; Chen, X. Improve ethanol yield through minimizing glycerol yield in ethanol fermentation of Saccharomyces cerevisiae. Chin. J. Chem. Eng. 2008, 16, 620–625. [Google Scholar] [CrossRef]
- Kong, Q.-X.; Zhang, A.-L.; Cao, L.-M.; Chen, X. Over-expressing GLT1 in a gpd2 Delta mutant of Saccharomyces cerevisiae to improve ethanol production. Appl. Microbiol. Biotechnol. 2007, 75, 1361–1366. [Google Scholar] [CrossRef]
- Hubmann, G.; Guillouet, S.; Nevoigt, E. Gpd1 and Gpd2 fine-tuning for sustainable reduction of glycerol formation in Saccharomyces cerevisiae. Appl. Environ. Microbiol. 2011, 77, 5857–5867. [Google Scholar] [CrossRef] [Green Version]
- Luyten, K.; Albertyn, J.; Skibbe, W.F.; Prior, B.A.; Ramos, J.; Thevelein, J.M.; Hohmann, S. Fps1, a yeast member of the MIP family of channel proteins, is a facilitator for glycerol uptake and efflux and is inactive under osmotic stress. EMBO J. 1995, 14, 1360–1371. [Google Scholar] [CrossRef]
- Oliveira, R.; Lages, F.; Silva-Graca, M.; Lucas, C. Fps1p channel is the mediator of the major part of glycerol passive diffusion in Saccharomyces cerevisiae: Artefacts and re-definitions. Biochim. Biophys. Acta-Biomembr. 2003, 1613, 57–71. [Google Scholar] [CrossRef] [Green Version]
- Tamás, M.J.; Luyten, K.; Sutherland, F.C.W.; Hernandez, A.; Albertyn, J.; Valadi, H.; Li, H.; Prior, B.A.; Kilian, S.G.; Ramos, J.; et al. Fps1p controls the accumulation and release of the compatible solute glycerol in yeast osmoregulation. Mol. Microbiol. 1999, 31, 1087–1104. [Google Scholar] [CrossRef] [PubMed]
- Van Aalst, A.C.A.; de Valk, S.C.; van Gulik, W.M.; Jansen, M.L.A.; Pronk, J.T.; Mans, R. Pathway engineering strategies for improved product yield in yeast-based industrial ethanol production. Synth. Syst. Biotechnol. 2022, 7, 554–566. [Google Scholar] [CrossRef] [PubMed]
- Maestre, O.; Garcia-Martinez, T.; Peinado, R.A.; Mauricio, J.C. Effects of ADH2 overexpression in Saccharomyces bayanus during alcoholic fermentation. Appl. Environ. Microbiol. 2008, 74, 702–707. [Google Scholar] [CrossRef] [PubMed] [Green Version]
- Wang, J.Y.; Liu, W.; Ding, W.T.; Zhang, G.C.; Liu, J.J. Increasing ethanol titer and yield in a gpd1 Delta gpd2 Delta strain by simultaneous overexpression of GLT1 and STL1 in Saccharomyces cerevisiae. Biotechnol. Lett. 2013, 35, 1859–1864. [Google Scholar] [CrossRef] [PubMed]
- Liu, K.; Yuan, X.; Liang, L.M.; Fang, J.P.; Chen, Y.Q.; He, W.J.; Xue, T. Using CRISPR/Cas9 for multiplex genome engineering to optimize the ethanol metabolic pathway in Saccharomyces cerevisiae. Biochem. Eng. J. 2019, 145, 120–126. [Google Scholar] [CrossRef]
- Bao, Z.H.; Xiao, H.; Lang, J.; Zhang, L.; Xiong, X.; Sun, N.; Si, T.; Zhao, H.M. Homology-Integrated CRISPR-Cas (HI-CRISPR) system for one-step multigene disruption in Saccharomyces cerevisiae. ACS Synth. Biol. 2015, 4, 585–594. [Google Scholar] [CrossRef]
- Ferreira, R.; Skrekas, C.; Nielsen, J.; David, F. Multiplexed CRISPR/Cas9 genome editing and gene regulation using Csy4 in Saccharomyces cerevisiae. ACS Synth. Biol. 2018, 7, 10–15. [Google Scholar] [CrossRef]
- Jakounas, T.; Sonde, I.; Herrgard, M.; Harrison, S.J.; Kristensen, M.; Pedersen, L.E.; Jensen, M.K.; Keasling, J.D. Multiplex metabolic pathway engineering using CRISPR/Cas9 in Saccharomyces cerevisiae. Metab. Eng. 2015, 28, 213–222. [Google Scholar] [CrossRef]
- Fukunaga, T.; Cha-aim, K.; Hirakawa, Y.; Sakai, R.; Kitagawa, T.; Nakamura, M.; Nonklang, S.; Hoshida, H.; Akada, R. Designed construction of recombinant DNA at the ura30 locus in the yeast Saccharomyces cerevisiae. Yeast 2013, 30, 243–253. [Google Scholar] [CrossRef]
- Montague, T.G.; Cruz, J.M.; Gagnon, J.A.; Church, G.M.; Valen, E. CHOPCHOP: A CRISPR/Cas9 and TALEN web tool for genome editing. Nucleic Acids Res. 2014, 42, W401–W407. [Google Scholar] [CrossRef] [PubMed] [Green Version]
- Gietz, R.D.; Schiestl, R.H. Large-scale high-efficiency yeast transformation using the LiAc/SS carrier DNA/PEG method. Nat. Protoc. 2007, 2, 38–41. [Google Scholar] [CrossRef] [PubMed]
- Zhang, G.C.; Kong, I.I.; Kim, H.; Liu, J.J.; Cate, J.H.D.; Jin, Y.S. Construction of a quadruple auxotrophic mutant of an industrial polyploid Saccharomyces cerevisiae strain by using RNA-guided Cas9 nuclease. Appl. Environ. Microbiol. 2014, 80, 7694–7701. [Google Scholar] [CrossRef] [PubMed] [Green Version]
- Perpelea, A.; Wijaya, A.W.; Martins, L.C.; Rippert, D.; Klein, M.; Angelov, A.; Peltonen, K.; Teleki, A.; Liebl, W.; Richard, P.; et al. Towards valorization of pectin-rich agro-industrial residues: Engineering of Saccharomyces cerevisiae for co-fermentation of D-galacturonic acid and glycerol. Metab. Eng. 2022, 69, 1–14. [Google Scholar] [CrossRef]
- Bressani, A.P.P.; Martinez, S.J.; Sarmento, A.B.I.; Borem, F.M.; Schwan, R.F. Organic acids produced during fermentation and sensory perception in specialty coffee using yeast starter culture. Food Res. Int. 2020, 128, 10. [Google Scholar] [CrossRef]
- Li, Y.C.; Zeng, W.Y.; Gou, M.; Sun, Z.Y.; Xia, Z.Y.; Tang, Y.Q. Transcriptome changes in adaptive evolution of xylose-fermenting industrial Saccharomyces cerevisiae strains with delta-integration of different xylA genes. Appl. Microbiol. Biotechnol. 2017, 101, 7741–7753. [Google Scholar] [CrossRef]
- Gao, C.B.; Fu, Q.; Su, B.F.; Zhou, S.; Liu, F.Q.; Song, L.; Zhang, M.; Ren, Y.C.; Dong, X.Y.; Tan, F.H.; et al. Transcriptomic profiling revealed the signatures of intestinal barrier alteration and pathogen entry in turbot (Scophthalmus maximus) following Vibrio anguillarum challenge. Dev. Comp. Immunol. 2016, 65, 159–168. [Google Scholar] [CrossRef]
- Lu, N.; Rice, R.W. Demand drivers and price supports for bioethanol use as fuel in the United States: A brief review. For. Prod. J. 2010, 60, 126–132. [Google Scholar] [CrossRef]
- Pagliardini, J.; Hubmann, G.; Alfenore, S.; Nevoigt, E.; Bideaux, C.; Guillouet, S.E. The metabolic costs of improving ethanol yield by reducing glycerol formation capacity under anaerobic conditions in Saccharomyces cerevisiae. Microb. Cell Factories 2013, 12, 29. [Google Scholar] [CrossRef] [Green Version]
- Yu, K.O.; Kim, S.W.; Han, S.O. Reduction of glycerol production to improve ethanol yield in an engineered Saccharomyces cerevisiae using glycerol as a substrate. J. Biotechnol. 2010, 150, 209–214. [Google Scholar] [CrossRef]
- Lee, J.; Reiter, W.; Dohnal, I.; Gregori, C.; Beese-Sims, S.; Kuchler, K.; Ammerer, G.; Levin, D.E. MAPK Hog1 closes the S. cerevisiae glycerol channel Fps1 by phosphorylating and displacing its positive regulators. Genes Dev. 2013, 27, 2590–2601. [Google Scholar] [CrossRef] [PubMed] [Green Version]
- Guo, Z.P.; Zhang, L.; Ding, Z.Y.; Wang, Z.X.; Shi, G.Y. Interruption of glycerol pathway in industrial alcoholic yeasts to improve the ethanol production. Appl. Microbiol. Biotechnol. 2009, 82, 287–292. [Google Scholar] [CrossRef] [PubMed]
- Zhang, A.; Kong, Q.; Cao, L.; Chen, X. Effect of FPS1 deletion on the fermentation properties of Saccharomyces cerevisiae. Lett. Appl. Microbiol. 2007, 44, 212–217. [Google Scholar] [CrossRef] [PubMed]
- Xue, T.; Liu, K.; Chen, D.; Yuan, X.; Fang, J.P.; Yan, H.S.; Huang, L.Q.; Chen, Y.Q.; He, W.J. Improved bioethanol production using CRISPR/Cas9 to disrupt the ADH2 gene in Saccharomyces cerevisiae. World J. Microbiol. Biotechnol. 2018, 34, 154. [Google Scholar] [CrossRef]
- Wang, P.M.; Zheng, D.Q.; Ding, R.; Chi, X.Q.; Tao, X.L.; Min, H.; Wu, X.C. Improvement of ethanol production in Saccharomyces cerevisiae by hetero-expression of GAPN and FPS1 deletion. J. Chem. Technol. Biotechnol. 2011, 86, 1205–1210. [Google Scholar] [CrossRef]
- He, W.; Ye, S.; Xue, T.; Xu, S.; Li, W.; Lu, J.; Cao, L.; Ye, B.; Chen, Y. Silencing the glycerol-3-phosphate dehydrogenase gene in Saccharomyces cerevisiae results in more ethanol being produced and less glycerol. Biotechnol. Lett. 2014, 36, 523–529. [Google Scholar] [CrossRef]
- Kong, Q.X.; Gu, J.G.; Cao, L.M.; Zhang, A.L.; Chen, X.; Zhao, X.M. Improved production of ethanol by deleting FPS1 and over-expressing GLT1 in Saccharomyces cerevisiae. Biotechnol. Lett. 2006, 28, 2033–2038. [Google Scholar] [CrossRef]
- Wei, N.; Xu, H.; Kim, S.R.; Jin, Y.-S. Deletion of FPS1, encoding aquaglyceroporin Fps1p, improves xylose fermentation by engineered Saccharomyces cerevisiae. Appl. Environ. Microbiol. 2013, 79, 3193–3201. [Google Scholar] [CrossRef] [Green Version]
- Bai, F.W.; Anderson, W.A.; Moo-Young, M. Ethanol fermentation technologies from sugar and starch feedstocks. Biotechnol. Adv. 2008, 26, 89–105. [Google Scholar] [CrossRef]

| Primers | Sequence | Description |
| GPD2-gRNA-F1 | TGATTGGTTCTGGTAACTGGGGGGTTTTAGAGCTAGAAATAGCAAG | GPD2-gRNA vector construction |
| GPD2-gRNA-R1 | CCCCCAGTTACCAGAACCAATCAGATCATTTATCTTTCACTGCGGA | |
| Fps1-gRNA-F1 | AATAAGCAGTCATCCGACGAAGGGTTTTAGAGCTAGAAATAGCAAG | FPS1-gRNA vector construction |
| Fps1-gRNA-R1 | CCTTCGTCGGATGACTGCTTATTGATCATTTATCTTTCACTGCGGA | |
| ADH2-gRNA-F1 | GGAAACATTGATGATACCGTGGGGTTTTAGAGCTAGAAATAGCAAG | ADH2-gRNA vector construction |
| ADH2-gRNA-R1 | CCCACGGTATCATCAATGTTTCCGATCATTTATCTTTCACTGCGGA | |
| Us-TV-AFB1D | 5′-ATGGCTCGCGCGAAGTACTC-3′ | 2091 bp |
| Ds-TV-AFB1D | 5′-TTAAAGCTTCCGCTCTATGAA-3′ | |
| Us-OM-PLA1 | 5′-TATGCGCATTTTGTCAGGGA-3′ | 879 bp |
| Ds-OM-PLA1 | 5′-GATTACATAATATCGTTCAGC-3′ | |
| Us-DPE | 5′-CAGAAAAGCGAAAGAGACACC-3′ | 910 bp |
| Ds-DPE | 5′-TGAGGATATTATCGCAAATC-3′ |
| Metabolites | Strains (C·mol/L) | ||||
|---|---|---|---|---|---|
| WT | SCG | SCF | SCGF | SCGFA | |
| Ethanol | 0.84204 | 0.89691 | 0.91013 | 0.96439 | 1.00517 |
| Glycerin | 0.07333 | 0.05827 | 0.05638 | 0.05468 | 0.05667 |
| Lactic acid | 0.00025 | 0.00024 | 0.00021 | 0.00023 | 0.00022 |
| Acetic acid | 0.00413 | 0.00387 | 0.00373 | 0.00383 | 0.00380 |
| Succinic acid | 0.00066 | 0.00059 | 0.00055 | 0.00055 | 0.00053 |
| CO2 | 0.02570 | 0.02541 | 0.02527 | 0.02507 | 0.02489 |
| Total | 0.94611 | 0.98529 | 0.99627 | 1.04875 | 1.09128 |
| Mutated Gene | Ethanol Yield | Glycerol Yield | References |
|---|---|---|---|
| GPD2Δ | ↑5.1% | ↓20.5% | this study |
| FPS1Δ | ↑6.6% | ↓23.1% | this study |
| GPD2Δ FPS1Δ | ↑13.3% | ↓25.4% | this study |
| GPD2Δ FPS1Δ ADH2Δ | ↑17.9% | ↓22.7% | this study |
| GPD2Δ | ↑7.41% | ↓7.95% | [32] |
| FPS1Δ | ↑10% | ↓18.8% | [33] |
| FPS1Δ GAPNΔ | ↑9.18% | ↓21.47% | [35] |
| GPD1 ▼ | ↑9.7% | ↓19% | [36] |
| FPS1Δ | ↑10% | ↓24% | [37] |
| FPS1Δ GLT1○ | ↑14% | ↓30% | [37] |
| FPS1Δ | ↑3% | --- | [38] |
Publisher’s Note: MDPI stays neutral with regard to jurisdictional claims in published maps and institutional affiliations. |
© 2022 by the authors. Licensee MDPI, Basel, Switzerland. This article is an open access article distributed under the terms and conditions of the Creative Commons Attribution (CC BY) license (https://creativecommons.org/licenses/by/4.0/).
Share and Cite
Yang, P.; Jiang, S.; Jiang, S.; Lu, S.; Zheng, Z.; Chen, J.; Wu, W.; Jiang, S. CRISPR-Cas9 Approach Constructed Engineered Saccharomyces cerevisiae with the Deletion of GPD2, FPS1, and ADH2 to Enhance the Production of Ethanol. J. Fungi 2022, 8, 703. https://doi.org/10.3390/jof8070703
Yang P, Jiang S, Jiang S, Lu S, Zheng Z, Chen J, Wu W, Jiang S. CRISPR-Cas9 Approach Constructed Engineered Saccharomyces cerevisiae with the Deletion of GPD2, FPS1, and ADH2 to Enhance the Production of Ethanol. Journal of Fungi. 2022; 8(7):703. https://doi.org/10.3390/jof8070703
Chicago/Turabian StyleYang, Peizhou, Shuying Jiang, Suwei Jiang, Shuhua Lu, Zhi Zheng, Jianchao Chen, Wenjing Wu, and Shaotong Jiang. 2022. "CRISPR-Cas9 Approach Constructed Engineered Saccharomyces cerevisiae with the Deletion of GPD2, FPS1, and ADH2 to Enhance the Production of Ethanol" Journal of Fungi 8, no. 7: 703. https://doi.org/10.3390/jof8070703
APA StyleYang, P., Jiang, S., Jiang, S., Lu, S., Zheng, Z., Chen, J., Wu, W., & Jiang, S. (2022). CRISPR-Cas9 Approach Constructed Engineered Saccharomyces cerevisiae with the Deletion of GPD2, FPS1, and ADH2 to Enhance the Production of Ethanol. Journal of Fungi, 8(7), 703. https://doi.org/10.3390/jof8070703
